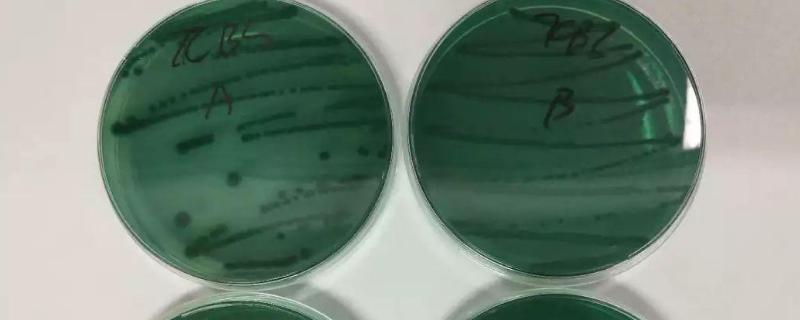

绿弧菌和黄弧菌都有害,但是绿弧菌的危害要大一点。弧菌的感染途径主要是口传播,其次是通过体表创伤和腮进入水产动物的体内。其实很多水产动物吃的食物也有弧菌存在,比如沙蚕。在虾母阶段,如果给其吃沙蚕,就会容易感染弧菌。还有丰年虫体内也有弧菌,在给水产动物喂丰年虫时,一定要控制弧菌。
一、绿弧菌和黄弧菌哪个有害
1、绿弧菌和黄弧菌都有害,但是绿弧菌的危害要大一点。弧菌的感染途径主要是口传播,其次是通过体表创伤和腮进入水产动物的体内。预防绿弧菌和黄弧菌可以全塘泼洒石灰水,这是处理弧菌超标时使用的一种好方法。当水环境中的弧菌数量超过理论阀值时,但水体中总异养菌的数量达到弧菌数量的30倍以上,这时兑水产动物还是安全的,但也要定期泼蛭弧菌和复合丁酸梭菌等多种有益菌。
2、很多水产动物的食物可能会携带绿弧菌和黄弧菌。以虾为例,在虾母阶段,如果给其吃沙蚕,就很容易感染弧菌。为此,建议在虾母池使用微生物制剂控制弧菌数量,同时洗卵,这能提高孵化出的幼体后期培育成活率。
3、如果在培育虾幼体时给其使用丰年虫,这时就一定要控制弧菌。在这个阶段一定要使用正确的化学方法控制,否则就有可能会影响到对虾幼体肠道细胞发育,从而造成对虾出现大面积“空肠空胃”的症状。
二、绿弧菌对鱼有什么影响
1、绿弧菌会使鱼产生弧菌病,这种病是海水鱼类最常发生的细菌性疾病。弧菌病共同的病症是鱼体表皮肤溃疡,感染初期,体色也会呈斑块状褪色,鱼会食欲不振,缓慢的游动于水面上;中度感染时,鱼鳍基部、躯干部等会出现斑点状出血。
2、防治绿弧菌时在前30-40天之前,要特别注重鱼肝胰脏的发育和转化,转肝顺利,肝脏功能完整,鱼体的免疫力就会好,不容易感染弧菌。即使池水中存在少量弧菌,鱼也不一定会发病。
3、当发现鱼有弧菌初期感染症状时,比如身上的颜色深有斑点,这表明病情药剂要开始恶化。这时一定要及时泼洒em菌护肝护肠,杀灭肝胰脏、肠胃中的弧菌,避免进一步感染。
